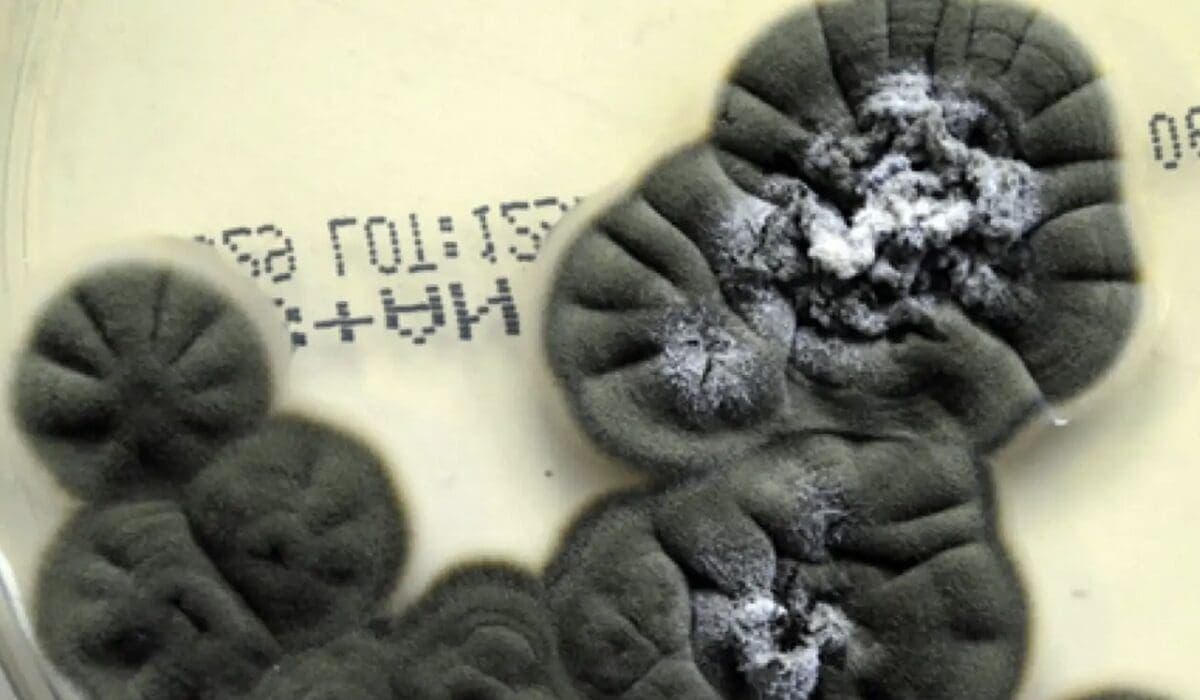
Hongo de Chernóbil podría convertirse en un escudo natural contra la radiación en el espacio

Surgen los rayos X a color y en tercera dimensión
Una compañía en Nueva Zelanda de nombre Mars Bioimaging, ha creado un nuevo avance dentro de las ciencias médicas, pues han descubierto los rayos X a color y en tercera dimensión, con lo cual se puede ver a detalle todo lo que hay dentro de nuestro organismo.
C
Carlos Espejel·
348Compartir
Una compañía en Nueva Zelanda de nombre Mars Bioimaging, ha creado un nuevo avance dentro de las ciencias médicas, pues han descubierto los rayos X a color y en tercera dimensión, con lo cual se puede ver a detalle todo lo que hay dentro de nuestro organismo.
De acuerdo con Mars Biomaging, este es el avance más importante hasta la fecha en cuanto a tecnología CERN o rayos X se refiere, pues las imágenes se pueden ver a color sobre huesos músculos y el resto del tejido humano, además de ser tridimensionales.
Esta nueva tecnología, se basa, según expertos, en el chip "Medipix3", el cual fue desarrollado por el CERN; pero, modificado con algoritmos de procesamiento de datos por parte de los científicos neozelandeses.
Tras las modificaciones, consiguieron identificar que los rayos X pueden atravesar diversas longitudes de onda a partir de que pasan los tejidos humanos; llegando así más allá del hueso, lo cual no era posible con las radiografías tradicionales, ya que sólo son capaces de atravesar los tejidos blandos produciendo una imagen plana en un tono blanco y negro.
También te puede interesar: Los cabezazos de los futbolistas podrían causar demencia, según la ciencia
Esto se debe a que la longitud de onda es más corta que la luz visible. Sin embargo, ahora, la nueva tecnología llamada "Spectral CT", puede medir longitudes de onda más largas y con ello interpretar más datos que arrojan una imagen en 3D y a color.
¿Qué te pareció?